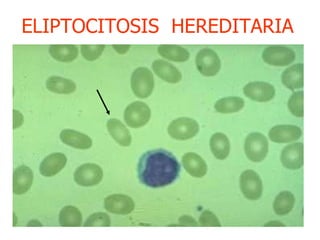
ELIPTOCITOSIS  HEREDITARIA
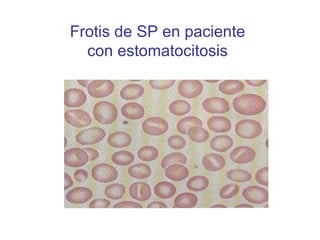
Frotis de SP en paciente con estomatocitosis
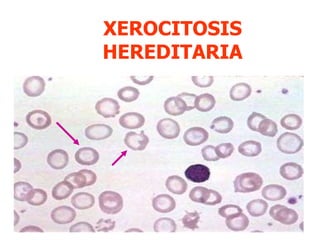
XEROCITOSIS HEREDITARIA
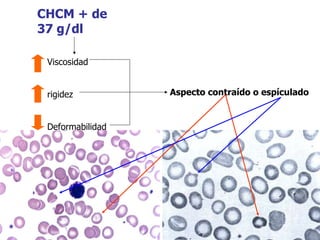
CHCM + de 37 g/dl Viscosidad rigidez Deformabilidad Aspecto contraído o espículado
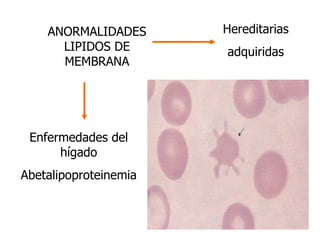
ANORMALIDADES LIPIDOS DE MEMBRANA Hereditarias adquiridas Enfermedades del hígado Abetalipoproteinemia

El documento describe diferentes tipos de anemias hemolíticas hereditarias causadas por defectos en la membrana eritrocitaria, incluyendo esferocitosis hereditaria, eliptocitosis hereditaria, piroquilocitosis hereditaria, estomatocitosis hereditaria y xerocitosis hereditaria. Estos trastornos se deben a mutaciones genéticas que afectan las proteínas de la membrana eritrocitaria y conducen a anormalidades en la forma, estabilidad, permeabilidad y funcionalidad de los eritrocitos.

![ESTOMATOCITOSIS HEREDITARIA Anemia Hemolítica autosómica dominante K+ [ ] intracelular de cationes Células sobrehidratadas H 2 O intracelular E stomatocitos e Membrana anormalmente permeable Na+ Excede la capacidad de la bomba de cationes](https://image.slidesharecdn.com/ahdefectintrnsecos-100727102839-phpapp02/85/Ah-defect-intrinsecos-38-320.jpg)